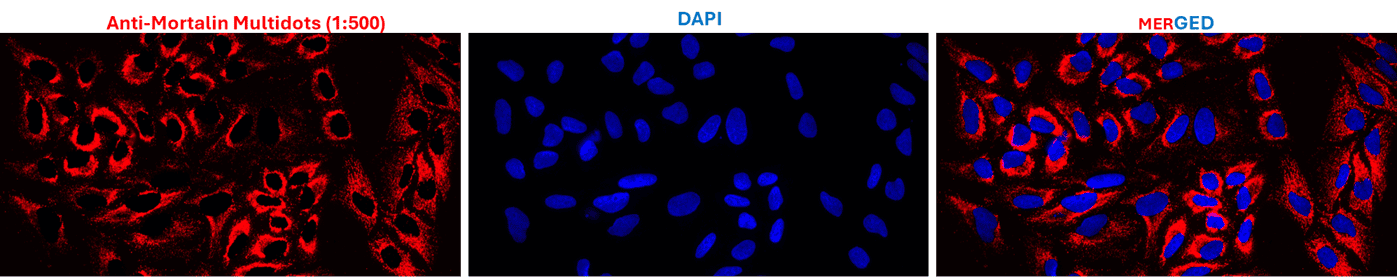
Imaging

Imaging
Reagents for Imaging
The fluorescence microscopy workflow is routinely disrupted by switching lasers to excite different organic dyes and the rapid photobleaching of reagents limits your analysis timeframe.
Quantum dots protected in a polymer provides greater stability so you can take advantage of their inherent bright fluorescence and illuminate all the colors in your sample with one laser. One can spend more time analyzing and less time setting up lasers.

Incorporate MultiDots and MagDots in your Panel
Reagents
Design Your Panel
Applications
Applications
Imaging Host Immune Cells with MagDots
Immune cells of a host squid (hemocytes) can be reintroduced into the host animal and be tracked with downstream applications, such as fluorescence and magnetic particle imaging, or manipulated with techniques such as magnetic tweezers. Here, hemocytes labelled with MagDot 610 PEG by researchers from University of Florida is shown.
Example protocol may be found in dx.doi.org/10.17504/protocols.io.36wgq36z3lk5/v1

Staining HeLa cells with Multidot-conjugated anti-Mortalin antibody
MultiDots can be used in Immunocytochemistry to assess the presence of a specific protein or antigen in cells by use of a specific antibody that binds to it. The antibody allows visualization of the protein under a microscope. Here, HeLa cells labelled with Multidot conjugated AntiMortalin was used to detect the presence of Mortalin by Antibodies Incorporated.